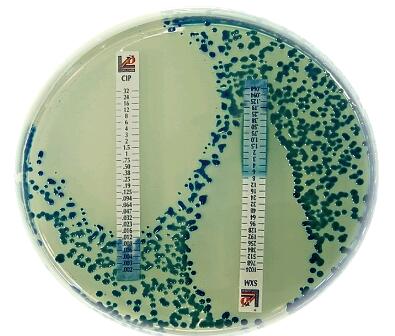
产品封面图

相关产品推荐更多 >
万千商家帮你免费找货
0 人在求购买到急需产品
- 详细信息
- 文献和实验
- 技术资料
- 供应商:
利飞驰
0.002 - 32 GEM
庆大霉素 0.016 - 256 CN
夫西地酸 0.016 - 256 FU
加替沙星 0.002 - 32 GAT
磷霉素(含葡萄糖-6-磷酸酶) 0.016 - 256 FOS
磷霉素(含葡萄糖-6-磷酸酶) 0.064 - 1024 FOS
红霉素 0.016 - 256 E
氟本尼考 0.016-256 FFC
0.016 - 256 DXT
恩氟沙星 0.002 - 32 ENR
厄他培南 0.002 - 32 ETP
达巴万星 ( FDA 批准) 0.002-32 DAL
达托霉素 (含 Ca2+) 0.016 - 256 DAP
粘菌素 0.016 - 256 CS
粘菌素 0.064 - 1024 CS
风险提示:丁香通仅作为第三方平台,为商家信息发布提供平台空间。用户咨询产品时请注意保护个人信息及财产安全,合理判断,谨慎选购商品,商家和用户对交易行为负责。对于医疗器械类产品,请先查证核实企业经营资质和医疗器械产品注册证情况。
文献和实验佚名 林可霉素(lincomycin)由链丝菌(S. -lincolensis)产生,克林霉素(clindamycin )是林可霉素7位OH为Cl取代而成。两者具有相同的抗菌谱。由于克林霉素抗菌作用更强、口服吸收好且毒性较小,故临床较为常用。 【抗菌作用】两药对金葡菌(包括耐青霉素者)、溶血性链球菌、草绿色链球菌、肺炎球菌及大多数厌氧菌都有良好抗菌
女性上生殖道感染(盆腔炎)(pelvic inflammatory disease,PID)
盆腔炎是指女性一系列上生殖道炎症疾患,包括子宫内膜炎、输卵管炎、输卵管卵巢炎、盆腔腹膜炎和盆腔结缔组织炎。它是性传播疾病的最重要的也是最常见的并发症。 国外资料每年PID发生率接近100万人,国内尚缺少相应统计资料。 一、 引起PID的病原体 (一)需氧菌 1. 金黄色葡萄球菌(G+球菌):此菌致病力最强,对青霉素及克林霉素、万古霉素敏感。 2. 链球菌(G+球菌):乙型链球菌致病力最强,可造成新生
阿齐霉素及其他 阿齐霉素(azithromycin)与罗红霉素(roxithromycin)是近年用于临床的大环内酯类新品种,其抗菌谱和抗菌作用与红霉素相近或稍差,但具有良好的药动学特性,如罗红霉素血及组织浓度高,并衰期长(12~14小时),从而可降低用量,减少给药次数(每日1~2次),减少不良反应。 二、林可霉素及克林霉素 林可霉素(lincomycin)由链丝菌(S. -lincolensis)产生,克林霉素(clindamycin )是林可霉素7位OH为Cl